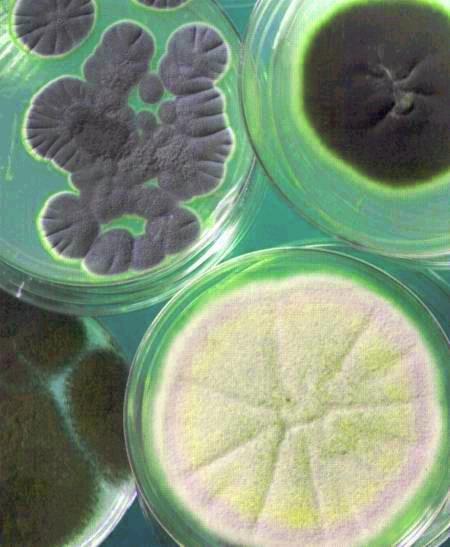
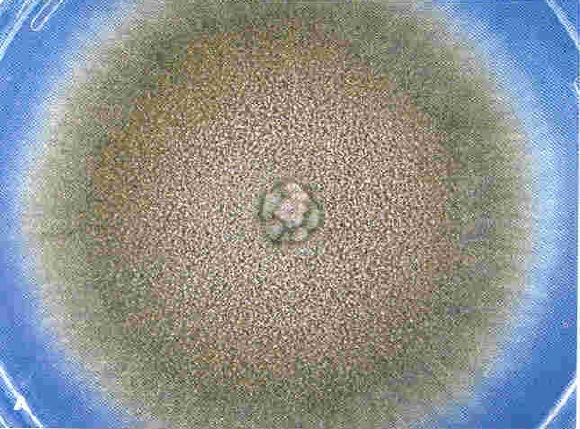

真菌的特点与类群
上一节
下一节
一、真菌的特点

真核微生物,具有细胞核,细胞较大;具有细胞壁
细胞壁的成份:真菌--几丁质;细菌--胞壁酸;植物--纤维素
从进化上看,真菌可能更加接近动物,而不是植物。
二、真菌的类群
1、酵 母 菌
最早为人利用的微生物-- “ 第一种家养微生物”;单细胞真菌;约700种,分布广泛
主要通过发酵糖类产生能量,喜糖喜酸;出芽生殖或分裂生殖;有些酵母菌能致病。

酵母菌的细胞结构


酵母菌的出芽生殖


可以根据出芽斑的数量来推测酵母细胞的寿命,研究其衰老过程
性别的出现:酵母菌的有性繁殖

酿酒酵母--细胞工厂
传统:酿酒、面制品加工;现代:单细胞蛋白、核酸、酶、维生素等
基因工程生产药物:乙肝疫苗;分子生物学研究的重要模式生物和工具
最早测定全基因组序列的真核生物(1996年)
2. 丝状真菌--霉菌
真菌的主要代表
细胞排列成丝状,以分裂和产生孢子的方式进行繁殖
在自然界中扮演重要角色: 降解有机物; 提供植物营养; 生产酶、抗生素等; 引起植物、动物和人的疾病

霉菌的菌丝 :无隔菌丝、有隔菌丝

霉菌的菌落
霉菌的繁殖: 无性繁殖、 有性繁殖
繁殖过程:形成孢子,扩散传播
1)霉菌的无性繁殖:菌丝末端延伸生长,分裂;在一定条件下产生分生孢子--无性孢子

2)霉菌的有性繁殖 --有性孢子


参考书籍


